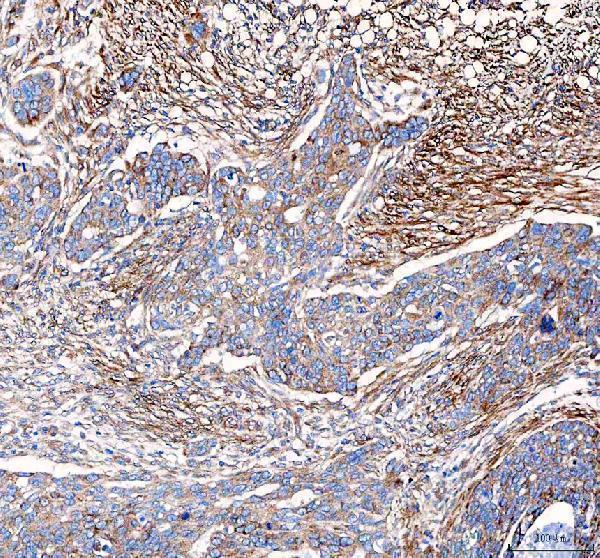
pb9071 vegfa primary antibodies ihc testing 1 IHC analysis of VEGF/VEGFA using anti-VEGF/VEGFA antibody (PB9071). 
VEGF/VEGFA was detected in a paraffin-embedded section of human ovarian serous adenocarcinoma tissue. Heat mediated antigen retrieval was performed in EDTA buffer (pH 8.0, epitope retrieval solution). The tissue section was blocked with 10% goat serum. The tissue section was then incubated with 2 μg/ml rabbit anti-VEGF/VEGFA Antibody (PB9071) overnight at 4°C. Peroxidase Conjugated Goat Anti-rabbit IgG was used as secondary antibody and incubated for 30 minutes at 37°C. The tissue section was developed using HRP Conjugated Rabbit IgG Super Vision Assay Kit (Catalog # SV0002) with DAB as the chromogen.

Product Info Summary
| SKU: | PB9071 |
|---|---|
| Size: | 100 μg/vial |
| Reactive Species: | Human, Mouse, Rat |
| Host: | Rabbit |
| Application: | Flow Cytometry, IHC, WB |
Product info
Product Name
Anti-VEGF/VEGFA Antibody Picoband®
!gene_name_link! !/gene_name_link!SKU/Catalog Number
PB9071
is an alternative SKU for this antibody, used in previous lots.
Size
100 μg/vial
Form
Lyophilized
Description
Boster Bio Anti-VEGF/VEGFA Antibody Picoband® catalog # PB9071. Tested in Flow Cytometry, IHC, WB applications. This antibody reacts with Human, Mouse, Rat. The brand Picoband indicates this is a premium antibody that guarantees superior quality, high affinity, and strong signals with minimal background in Western blot applications. Only our best-performing antibodies are designated as Picoband, ensuring unmatched performance.
Storage & Handling
Store at -20˚C for one year from date of receipt. After reconstitution, at 4˚C for one month. It can also be aliquotted and stored frozen at -20˚C for six months. Avoid repeated freeze-thaw cycles.
Cite This Product
Anti-VEGF/VEGFA Antibody Picoband® (Boster Biological Technology, Pleasanton CA, USA, Catalog # PB9071)
Host
Rabbit
Contents
Each vial contains 4 mg Trehalose, 0.9 mg NaCl and 0.2 mg Na2HPO4.
Clonality
Polyclonal
Clone Number
Isotype
Rabbit IgG
Immunogen
E.coli-derived human VEGF recombinant protein (Position: A27-R191). Human VEGF shares 78% amino acid (aa) sequence identity with both mouse and rat VEGF.
Cross-reactivity
No cross-reactivity with other proteins
Reactive Species
PB9071 is reactive to VEGFA in Human, Mouse, Rat
Reconstitution
Add 0.2ml of distilled water will yield a concentration of 500ug/ml.
Observed Molecular Weight
18, 27 kDa
Calculated molecular weight
Background of
VEGF, a homodimeric glycoprotein of relative molecular mass 45,000, is the only mitogen that specifically acts on endothelial cells. It may be a major regulator of tumor angiogenesis in vivo. It is, however, structurally related to platelet-derived growth factor. VEGF shares homology with the PDGF A chain and B chain, including conservation of all 8 cysteines found in PDGFA and PDGFB. VEGF gene contains 8 exons. VEGF induces remodeling and enhances TH2-mediated sensitization and inflammation in the lung. And this gene also can regulate haematopoietic stem cell survival by an internal autocrine loop mechanism. What’s more, it also stimulates neurogenesis in vitro and in vivo.
Antibody Validation
Boster validates all antibodies on WB, IHC, ICC, Immunofluorescence, and ELISA with known positive control and negative samples to ensure specificity and high affinity, including thorough antibody incubations.
Application & Images
Applications
PB9071 is guaranteed for Flow Cytometry, IHC, WB Boster Guarantee
Assay Dilutions Recommendation
The recommendations below provide a starting point for assay optimization. The actual working concentration varies and should be decided by the user.
Western blot, 0.1-0.5μg/ml, Human, Mouse, Rat
Immunohistochemistry (Paraffin-embedded Section), 2-5μg/ml, Human
Flow Cytometry (Fixed), 1-3μg/1x106 cells, Human
Positive Control
WB: human U87 whole cell, human K562 whole cell, rat brain tissue, rat C6 whole cell, mouse brain tissue, mouse Neuro-2a whole cell
IHC: human ovarian serous adenocarcinoma tissue, human lung cancer tissue
FCM: K562 cell
Validation Images & Assay Conditions
Recommended Resources
Here are featured tools and databases that you might find useful.
- Boster's Pathways Library
- Protein Databases
- Bioscience Research Protocol Resources
- Data Processing & Analysis Software
- Photo Editing Software
- Scientific Literature Resources
- Research Paper Management Tools
- Molecular Biology Software
- Primer Design Tools
- Bioinformatics Tools
- Phylogenetic Tree Analysis